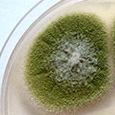

Jeżeli wiadomość jest nieczytelna, zobacz tutaj


Aktualności
 Ukazała się książka Czynniki szkodliwe w środowisku pracy. Wartości dopuszczalne 2024 (wydanie XIV zmienione) pod red. M. Pośniak, J. Skowroń. Uwzględniono w niej zmiany wprowadzone w latach 2023-2024 do polskiego prawa dotyczącego bezpieczeństwa i higieny pracy, a w szczególności do obowiązujących wartości najwyższych dopuszczalnych stężeń i natężeń czynników szkodliwych dla zdrowia w środowisku pracy.
Ukazała się książka Czynniki szkodliwe w środowisku pracy. Wartości dopuszczalne 2024 (wydanie XIV zmienione) pod red. M. Pośniak, J. Skowroń. Uwzględniono w niej zmiany wprowadzone w latach 2023-2024 do polskiego prawa dotyczącego bezpieczeństwa i higieny pracy, a w szczególności do obowiązujących wartości najwyższych dopuszczalnych stężeń i natężeń czynników szkodliwych dla zdrowia w środowisku pracy.
 21 stycznia 2025 r. Europejska Agencja Chemikaliów (ECHA) wpisała 5 nowych pozycji na listę kandydacką substancji stanowiących bardzo duże zagrożenie (SVHC). Obecnie lista kandydacka zawiera już 247 pozycji obejmujących substancje lub grupy substancji, które mogą być szkodliwe dla ludzi lub środowiska.
21 stycznia 2025 r. Europejska Agencja Chemikaliów (ECHA) wpisała 5 nowych pozycji na listę kandydacką substancji stanowiących bardzo duże zagrożenie (SVHC). Obecnie lista kandydacka zawiera już 247 pozycji obejmujących substancje lub grupy substancji, które mogą być szkodliwe dla ludzi lub środowiska.
 Zachęcamy do zgłaszania uwag do wstępnego projektu przewodnika nt. „Praktyczne wytyczne dotyczące informowania i szkolenia pracowników zajmujących się usuwaniem lub konserwacją azbestu”. Został on opracowywany przez konsorcjum kierowane przez Risk and Policy Analysis RPA Europe Prague s.r.o. (RPA Prague) i Risk & Policy Analysts Ltd (RPA Ltd) w ramach umowy z Komisją Europejską.
Zachęcamy do zgłaszania uwag do wstępnego projektu przewodnika nt. „Praktyczne wytyczne dotyczące informowania i szkolenia pracowników zajmujących się usuwaniem lub konserwacją azbestu”. Został on opracowywany przez konsorcjum kierowane przez Risk and Policy Analysis RPA Europe Prague s.r.o. (RPA Prague) i Risk & Policy Analysts Ltd (RPA Ltd) w ramach umowy z Komisją Europejską.
Zmiany w przepisach prawnych
 Przypominamy, że od stycznia 2025 obowiązują nowe wartości dopuszczalnych stężeń dla związków chromu(VI) w przeliczeniu na Cr(VI) (DzU 2020 poz. 61) i związków niklu w przeliczeniu na Ni (DzU 2024 poz. 1017). Metoda oznaczania związków niklu dostosowana do nowych wartości dopuszczalnych dla związków niklu w przeliczeniu na Ni została opublikowana w 2021 r. w kwartalniku „Podstawy i Metody Oceny Środowiska Pracy”.
Przypominamy, że od stycznia 2025 obowiązują nowe wartości dopuszczalnych stężeń dla związków chromu(VI) w przeliczeniu na Cr(VI) (DzU 2020 poz. 61) i związków niklu w przeliczeniu na Ni (DzU 2024 poz. 1017). Metoda oznaczania związków niklu dostosowana do nowych wartości dopuszczalnych dla związków niklu w przeliczeniu na Ni została opublikowana w 2021 r. w kwartalniku „Podstawy i Metody Oceny Środowiska Pracy”.
Zaproszenie do współpracy
 Pracownia Aerozoli, Filtracji i Wentylacji CIOP-PIB zaprasza do współpracy w ramach projektu badawczego NANO-AERO-WORK. Celem jest poszerzanie i upowszechnianie wiedzy na temat zawartości frakcji nano w aerozolach występujących w środowisku pracy. Biorąc udział w projekcie, przeprowadzone zostaną w Państwa zakładzie badania stężenia aerozoli metodą licznikową i grawimetryczną w powietrzu na stanowisku pracy, a ich wyniki zostaną Państwu udostępnione w postaci raportu.
Pracownia Aerozoli, Filtracji i Wentylacji CIOP-PIB zaprasza do współpracy w ramach projektu badawczego NANO-AERO-WORK. Celem jest poszerzanie i upowszechnianie wiedzy na temat zawartości frakcji nano w aerozolach występujących w środowisku pracy. Biorąc udział w projekcie, przeprowadzone zostaną w Państwa zakładzie badania stężenia aerozoli metodą licznikową i grawimetryczną w powietrzu na stanowisku pracy, a ich wyniki zostaną Państwu udostępnione w postaci raportu.
BIOINFO
Pracownia Zagrożeń Biologicznych oferuje ekspertyzy w zakresie oceny narażenia na szkodliwe czynniki biologiczne w środowisku pracy i w środowisku pozazawodowym, korozji biologicznej i działań remediacyjnych w budynkach, oceny stanu instalacji klimatyzacyjnych i wentylacyjnych pod kątem ich zanieczyszczenia aerozolami biologicznymi oraz badanie masek medycznych na zgodność z normą EN 14683:2019+AC.
Pracownia Zagrożeń Biologicznych oferuje ekspertyzy w zakresie oceny narażenia na szkodliwe czynniki biologiczne w środowisku pracy i w środowisku pozazawodowym, korozji biologicznej i działań remediacyjnych w budynkach, oceny stanu instalacji klimatyzacyjnych i wentylacyjnych pod kątem ich zanieczyszczenia aerozolami biologicznymi oraz badanie masek medycznych na zgodność z normą EN 14683:2019+AC.
###UNSUBSCRIBE_NOTE###





 Zachęcamy do zapoznania się z anglojęzyczną wersją bazy BIOINFO.
Zachęcamy do zapoznania się z anglojęzyczną wersją bazy BIOINFO.
